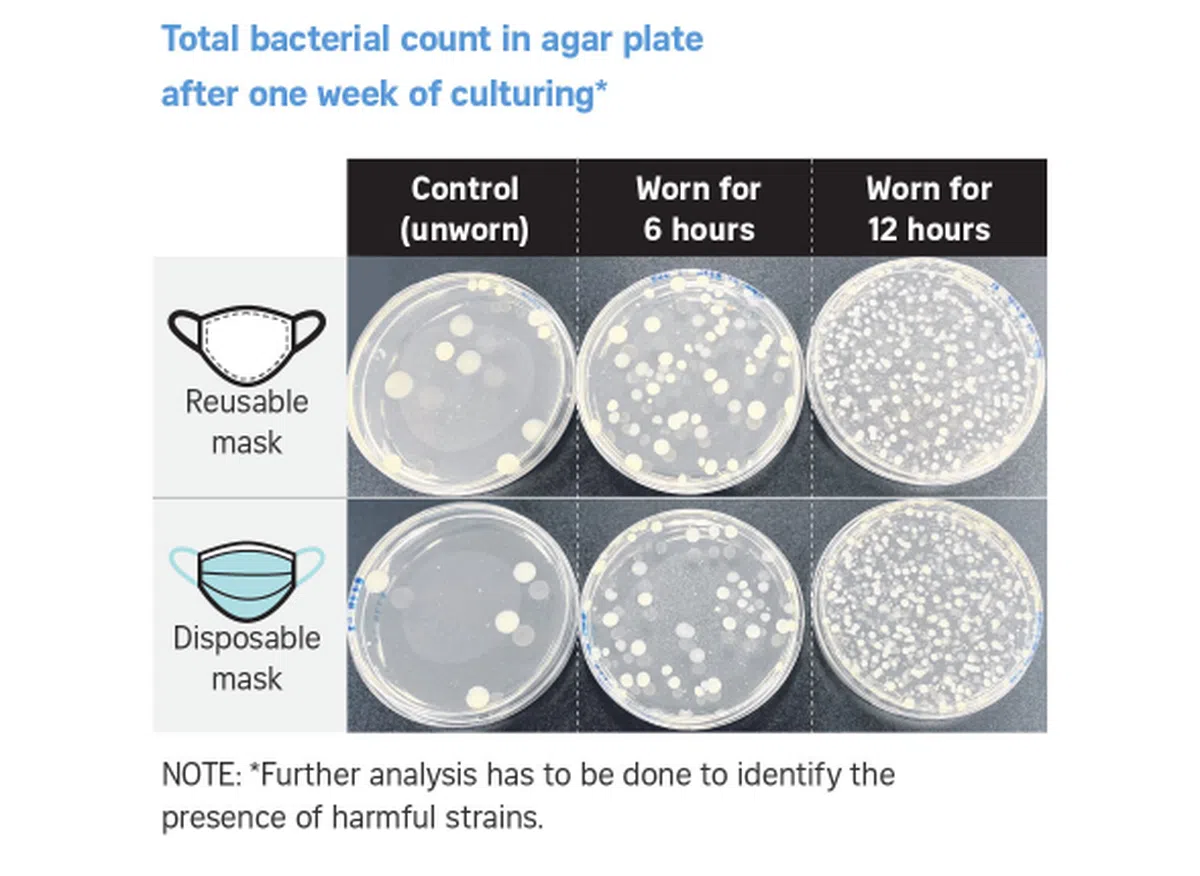
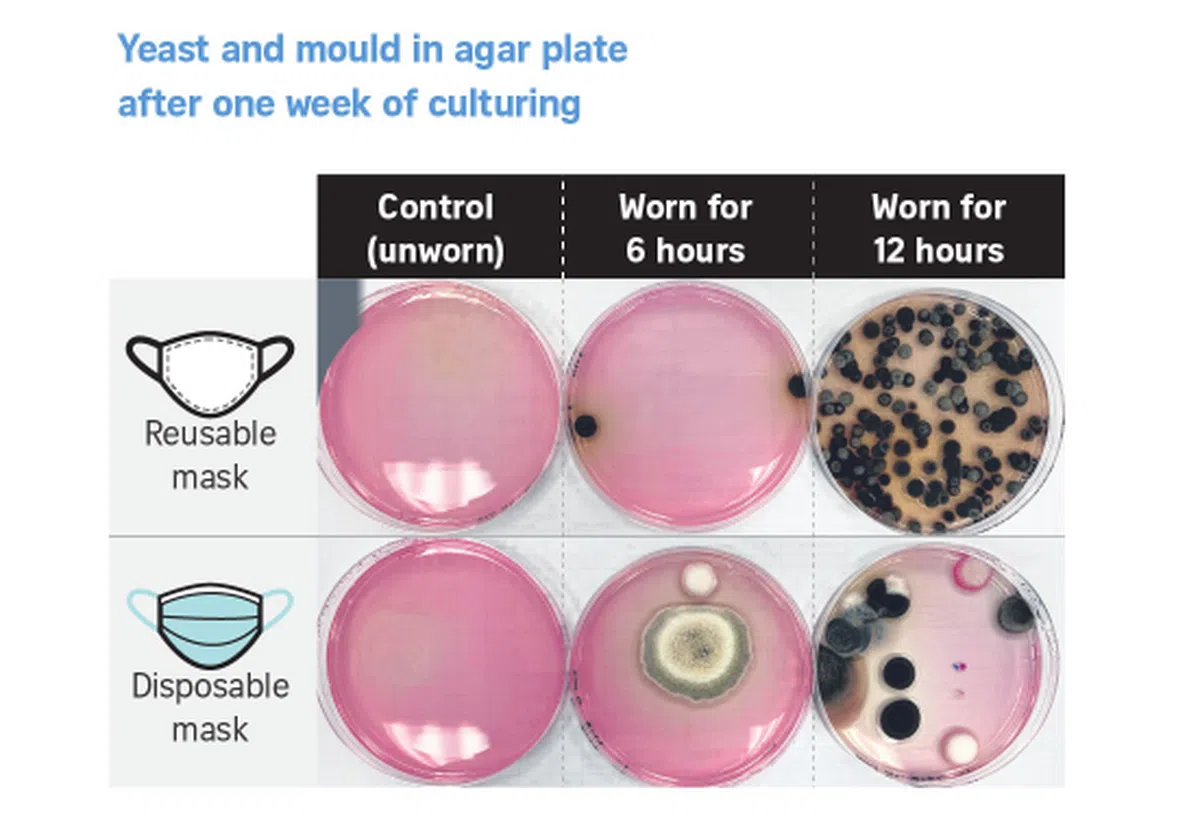
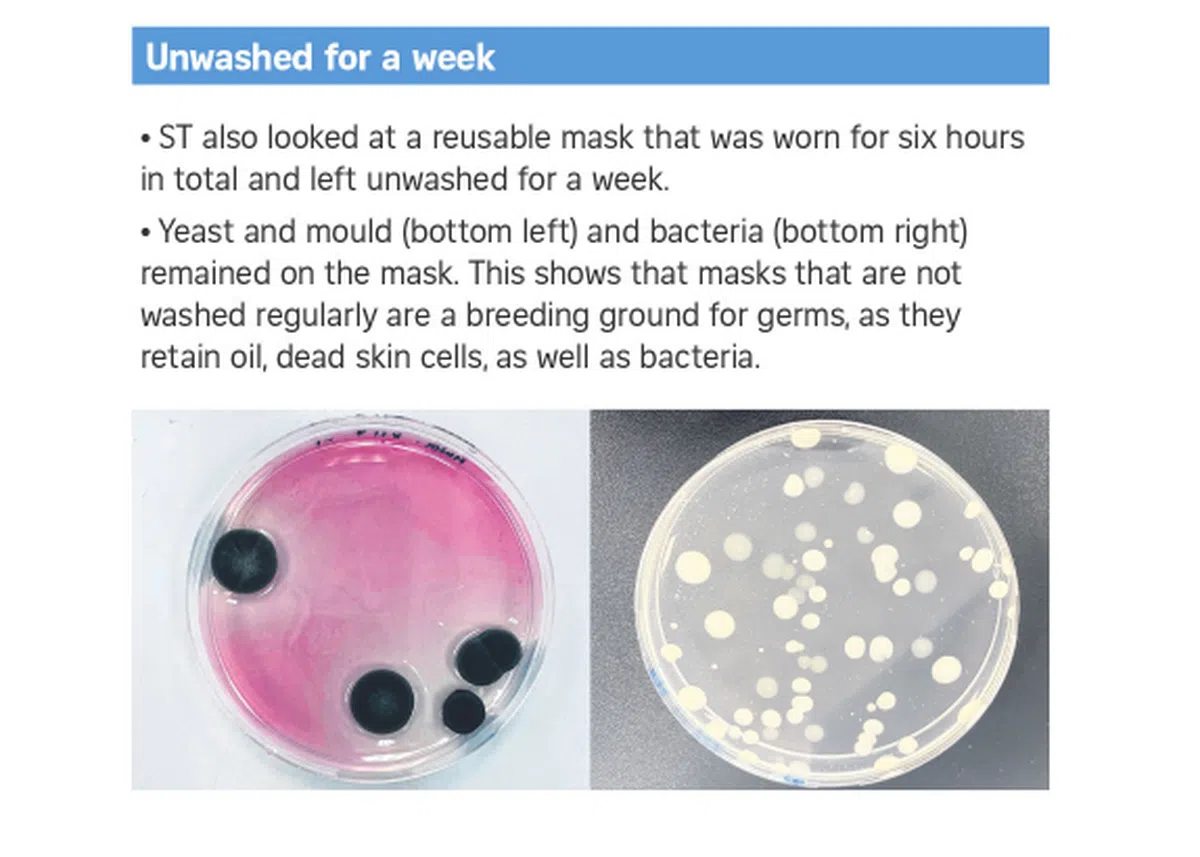

戴了一天的口罩会吸附多少微生物? 来看看究竟有多恐怖

不敢不洗了
疫情期间为了避免病毒传播,大家都已习惯了戴口罩的日子。尽管戴口罩能够有效防止病毒的传播,但你以为带上口罩就能高枕无忧了吗?
《海峡时报》近期与本地Eurofins实验室合作,研究在长时间佩戴口罩的情况下,口罩究竟会附上多少微生物(microbes),结果让人看了心里发毛头皮发痒。
Eurofins实验室的研究显示,反复佩戴的口罩时间越长,口罩内部的细菌、霉菌和酵母的数量都会增加。
该实验分别在一次性和可重复性使用的口罩上进行了六小时和十二小时的实验,记录了这段时间出现的细菌、酵母菌、霉菌、黄金色葡萄球菌(会导致皮肤感染的常见菌类)和绿农杆菌(导致出现皮疹的菌类),然后进行对比。

新加坡科学技术研究机构皮肤研究学者约翰·康蒙博士(Dr John Common)受访时说,黄金色葡萄球菌可能会产生一些对人类有害的毒素。
这些细菌可通过直接接触受感染的人,或者使用受污染的物品来传播。
因此,这种菌类被归类为一种致病生物,也就是说这种经常出现在健康人群中的菌类在某种程度下也会对人体造成伤害。
绿农杆菌则是另一种可以寄生在皮肤上,并对人体产生伤害的细菌。
好在所有经测试的口罩样本中,都没有发现黄金色葡萄球菌和绿农杆菌细胞的存在。
毫不意外的,研究者发现在那些戴了十二个小时的口罩上,酵母菌、霉菌和其他细菌的总数量,都要高于只戴了六小时的口罩。
值得注意的是,该研究发现,可重复使用的口罩普遍比一次性口罩含有更多的微生物。
目前还需进一步检测,才能确定依附在口罩上的其他微生物和细菌会否导致疾病或者皮肤病等。
本地微生物学家采访时告诉《海峡时报》,所有口罩内的温湿环境往往有利于微生物的滋生,但这些微生物并非都是有害的。
南洋理工大学食品科技计划主任陈维宁教授受访时说:
“由于我们周围的环境和消化系统(如:口腔和肠道)中都有微生物的存在,所以在口罩上发现这些微生物细菌并不奇怪。”
南洋理工学院化学与生命科学系院长李文坚博士则表示,这些口罩的材料,会导致在使用了十二个小时后截留一定数量的细菌。
他指出,一次性的口罩和可重复使用口罩的最大区别,就是最靠近嘴部的内衬布料。他说:
“这个最靠近嘴巴的内衬布料,是我们打喷嚏或者咳嗽时细菌残留的地方,当我们戴着口罩说话时,我们的口水会被雾化附着在这个布料上。”

李博士补充说,比起可重复使用的织布口罩,一次性的不织布口罩能提供更好的透气性和细菌过滤功能。织布口罩的纤维空间相对比较大,因此细菌的过滤性能也没有那么好。
因此,如果不经常清洗可重复使用的口罩,就会导致口罩内外都吸附上灰尘、污垢、汗水以及其他微生物(包括细菌)等。
“这些很可能会引起过敏、皮肤刺激或感染等问题。”
国大杨潞龄医学院微生物与免疫学系助理教授陈博士告诉记者,在“绝大多数病例”中,口罩上的细菌并不会造成太严重的后果,但偶尔会出现“机遇感染”。
这些寄生在皮肤上的细菌会在脏口罩上大量繁殖并引起疾病。陈博士说:
“细菌数量低的情况下,免疫系统会控制住它们。一旦数量高,则有可能引起轻微至严重的过敏反应、呼吸问题甚至鼻腔感染。”
陈博士指出,由于很难确定口罩上是否有存留有害细菌,所以建议大家还是经常清洗口罩或在每次戴一天口罩后就清洗。
看到口罩上的这些“突然看得见”的细菌,你是否还敢偷懒不洗口罩?反正红蚂蚁已经倒胃得连最爱的泡泡茶都不想喝了……(有get到的蚁粉跟红蚂蚁high-five一下)